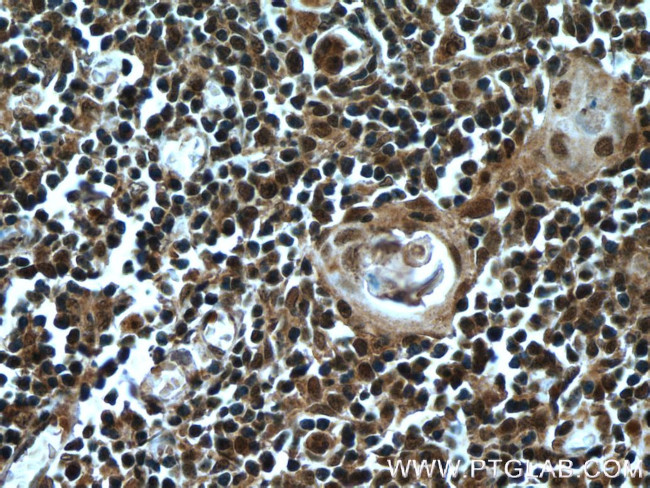
KDM4D Antibody in Immunohistochemistry (Paraffin) (IHC (P))
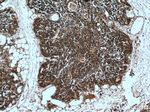
KDM4D Antibody in Immunohistochemistry (Paraffin) (IHC (P))

Search
Proteintech
KDM4D Polyclonal Antibody
{{$productOrderCtrl.translations['antibody.pdp.commerceCard.promotion.promotions']}}
{{$productOrderCtrl.translations['antibody.pdp.commerceCard.promotion.viewpromo']}}
{{$productOrderCtrl.translations['antibody.pdp.commerceCard.promotion.promocode']}}: {{promo.promoCode}} {{promo.promoTitle}} {{promo.promoDescription}}. {{$productOrderCtrl.translations['antibody.pdp.commerceCard.promotion.learnmore']}}
产品信息
22591-1-AP
种属反应
宿主/亚型
分类
类型
抗原
偶联物
形式
浓度
规格
纯化类型
保存液
内含物
保存条件
运输条件
产品详细信息
Immunogen sequence: RYDLWKRGQ DRAVVDHMEP RVPASQELST QKEVQLPRRA ALGLRQLPSH WARHSPWPMA ARSGTRCHTL VCSSLPRQSA VSGTATQPRA AAVHSSKKPS STPSSTPGPS AQIIHPSNGR RGRGRPPQKL RAQELTLQTP AKRPLLAGTT CTASGPEPEP LPEDGALMDK PVPLSPGLQH PVKASGCSWA PVP (332-523 aa encoded by BC122858)
靶标信息
The JMJD2D gene encodes a member of the Jumonji C domain-containing histone demethylases, which are involved in the epigenetic regulation of gene expression by demethylating lysine residues on histone proteins. JMJD2D specifically interacts with β-catenin and is implicated in colorectal cancer, where it activates transcription of target genes and promotes cell proliferation, migration, and tumor formation. Structurally, JMJD2D belongs to the JMJD2 family but exhibits distinct features, lacking certain regions that make it the most structurally divergent within the family. Additionally, JMJD2D stabilizes and cooperates with the hepatitis B virus protein HBx, facilitating cccDNA transcription by demethylating H3K9me3 and counteracting the repressive effects of p53. JMJD2D's role in various cellular processes highlights its importance in both cancer pathogenesis and viral replication, making it a potential target in therapeutic research for colorectal cancer and hepatitis B.
仅用于科研。不用于诊断过程。未经明确授权不得转售。
生物信息学
蛋白别名: [histone H3]-trimethyl-L-lysine(9) demethylase 4D; FLJ10251; JmjC domain-containing histone demethylation protein 3D; jumonji domain containing 2D; Jumonji domain-containing protein 2D; lysine (K)-specific demethylase 4D; Lysine-specific demethylase 4D; unnamed protein product
基因别名: JHDM3D; JMJD2D; KDM4D
UniProt ID: (Human) Q6B0I6
Entrez Gene ID: (Human) 55693